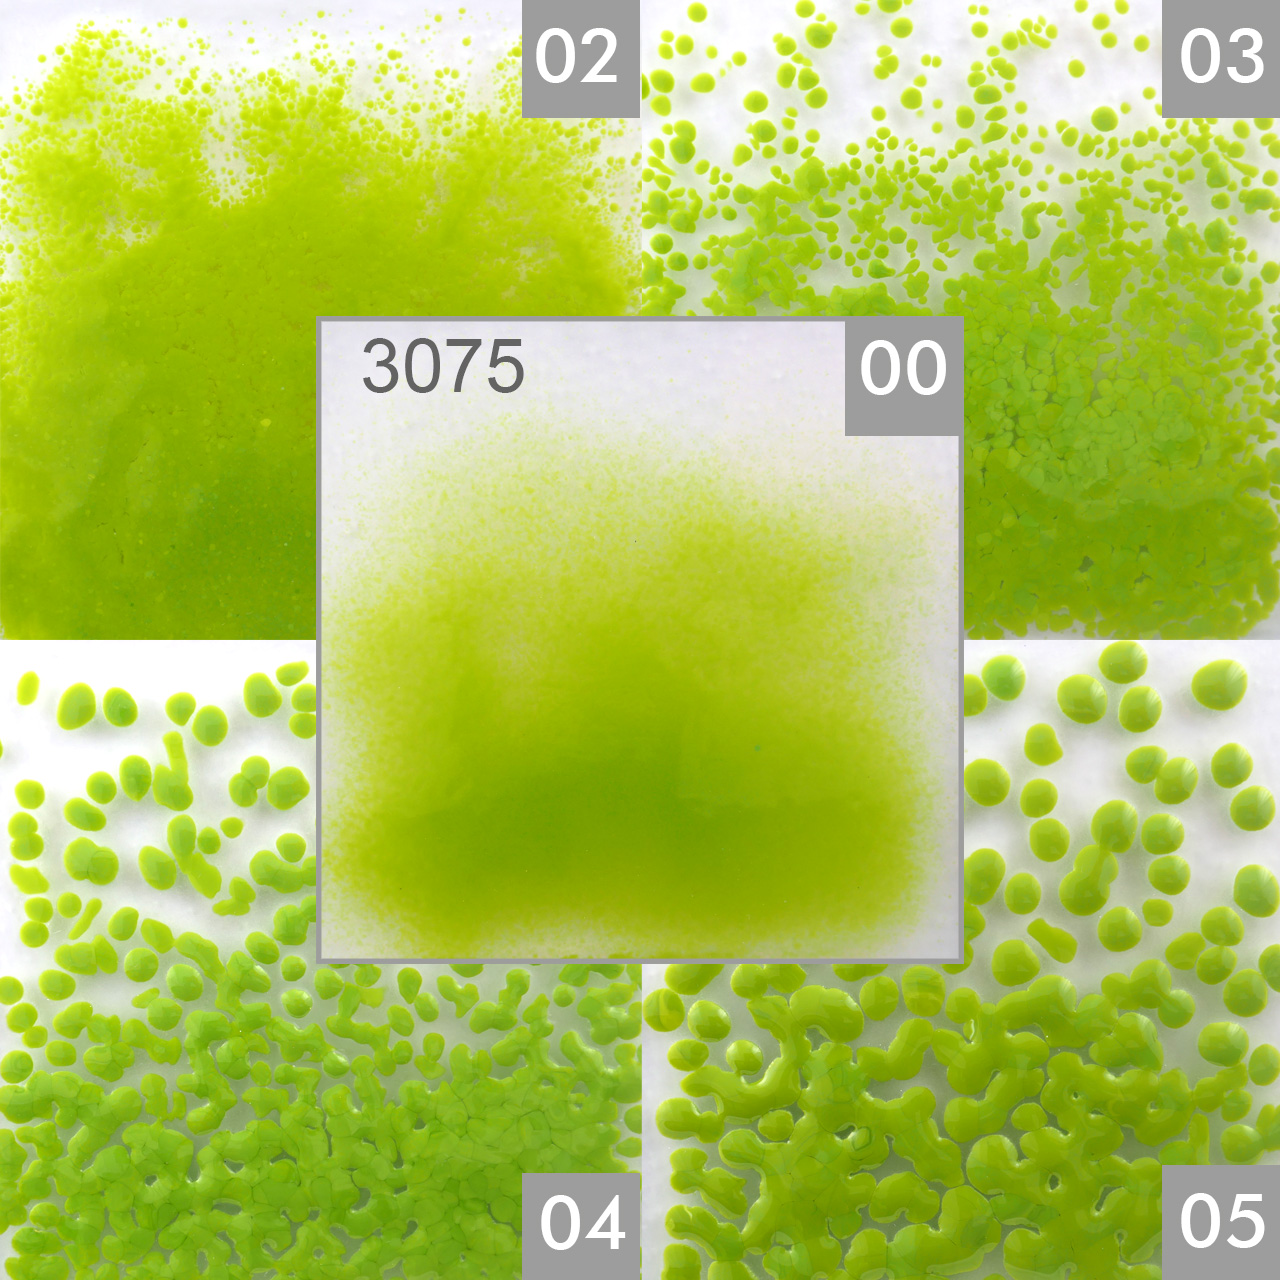
OPTUL FLOAT Frittes 3075 VE=15 kg K-0 OPTUL FLOAT Frittes 3075 VE=15 kg K-0

N° d'article: 3587470
OPTUL FLOAT Frittes 3075 VE=15 kg K-0
Les prix et la fonction d'achat ne sont visibles qu'après l'enregistrement du client professionnel.
OPTUL FLOAT Frittes 3075 VE=15 kg K-0
Opaline vert pistache
granulat 0,00 - 0,36mm